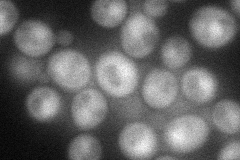
YHR109W
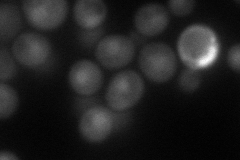
YHR109W
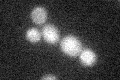
YHR109W

View description
Cytochrome c lysine methyltransferase, trimethylates residue 72 of apo-cytochrome c (Cyc1p) in the cytosol; not required for normal respiratory growth
Localization:
Intensity:
Fold change:
Significance:
-
C’ GFP library in SD

below threshold15.08 -
N' NOP1pr-GFP in SD
cytosol,nucleus49.5345 -
N' TEF2pr-mCherry in SD
nucleus60.5119 -
N' NATIVEpr-GFP in SD

below threshold22.7092 -
N' TEF2pr-VC and Cyto-VN in SD

cytosol41.4182 -
C’ GFP library in SD+DTT

cytosol17.131.13No -
C’ GFP library in SD+H2O2
cytosol15.281.01No -
C’ GFP library in Starvation Media

cytosol16.361.08No -
C’ GFP library on the background of Pup2-DaMP

below threshold -
C’ GFP library on the background of CCT mutant

below threshold17.57221.16462No
